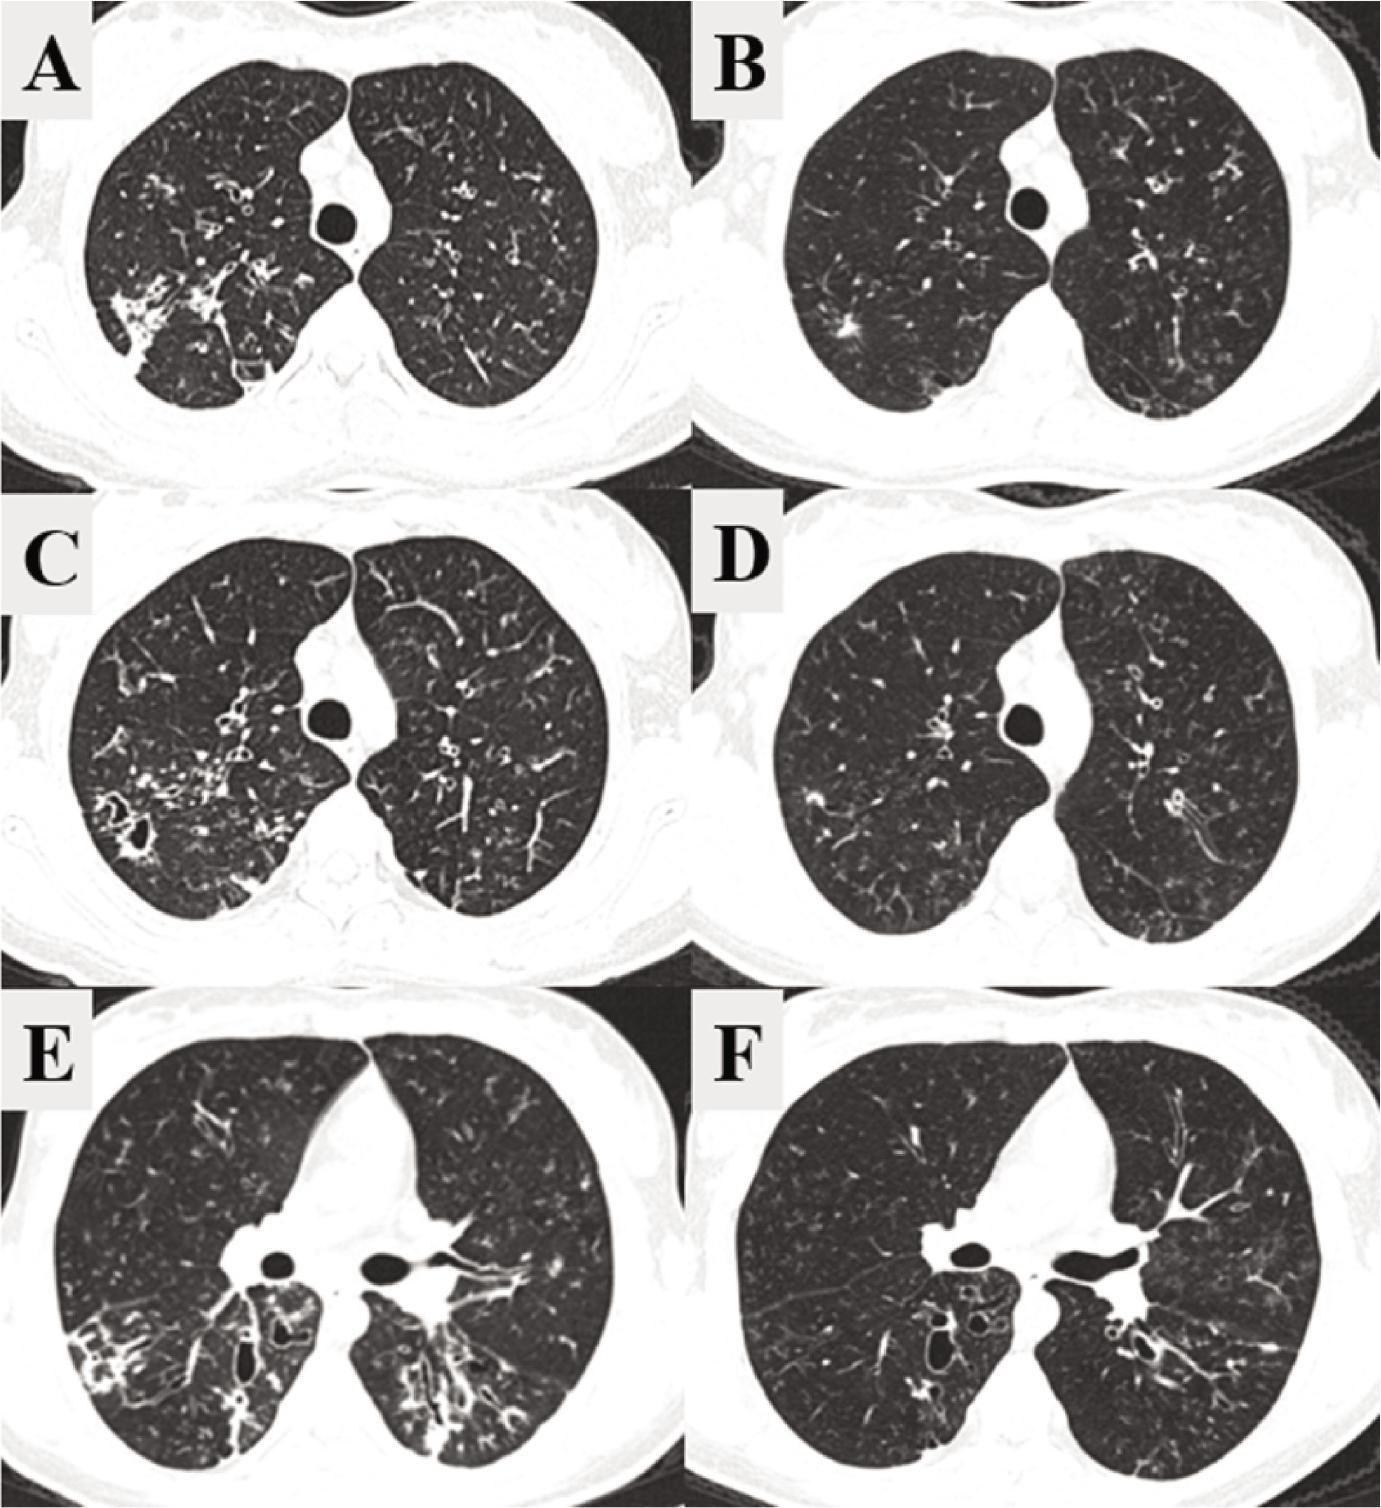

Figure 1.

Figure 2.

Figure 3.

Figure 4.
Figure 5.

Figure 6.

Figure 7.

Figure 8.

Figure 9.

Classes of CFTR gene mutations (5)_
| Type of mutation | Type of CFTR mutation | Percent of people with CF who have at least 1 mutation |
|---|---|---|
| Normal | CFTR protein is created and moves to the cell surface, allowing the transfer of chloride and water. | — |
| Class I | No functional CFTR protein is created | 22% |
| Class II | CFTR protein is created but misfolds, keeping it from moving to the cell surface. This is called a trafficking defect. | 88% |
| Class III | CFTR protein is created and moves to the cell surface but the channel gate does not open. This is called defective channel regulation. | 6% |
| Class IV | CFTR protein is created and moves to the cell surface but the channel function is faulty. This is called decreased channel conductance. | 6% |
| Class V | Normal CFTR protein is created and moves correctly to the cell surface but not enough amount of the protein. This is called reduced synthesis of CFTR. | 5% |
| Class VI | CFTR protein is created but it does not work properly at the cell membrane. This is called decreased CFTR stability. | 5% |
Statistically significant changes in group mean values of ppFEV1, sweat chloride test, and Bhalla score_
| Parameter | Pre | Post | Difference | 95% CI | p |
|---|---|---|---|---|---|
| ppFEV1 (%) | 82.79 | 96.16 | 13.38 | (6.5213, 20.2351) | 0.002 |
| Sweat test (mmol/L) | 111.55 | 68.45 | –43.09 | (-49.9478, -36.234) | < 0.001 |
| Total Bhalla score | 14.55 | 18.27 | 3.73 | (2.8511, 4.6035) | < 0.001 |
Interpretation of the Bhalla score (11)_
| Bhalla score | Disease severity |
|---|---|
| 16–25 points | Mild bronchiectasis |
| 9–15 points | Moderate bronchiectasis |
| 0–8 points | Severe bronchiectasis |
Comparison of mean values of CT parameters assessed before and after therapeutic intervention_
| Score | Pre | Post | Difference | 95% CI | p |
|---|---|---|---|---|---|
| Bronchiectasis | 1.73 | 1.36 | –0.36 | (–0.6479, –0.0794) | 0.125 |
| Wall thickening | 1.09 | 0.18 | –0.91 | (–1.3039, –0.5143) | 0.008 |
| Mucus plugging | 1.64 | 0.55 | –1.09 | (–1.3948, –0.7877) | 0.002 |
| Total Bhalla score | 14.55 | 18.27 | 3.73 | (2.8511, 4.6035) | < 0.001 |